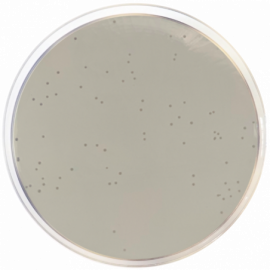

Selecciona un país
España
Estados Unidos
Afganistán
Albania
Andorra
Angola
Anguila
Antártida
Antigua y Barbuda
Antillas Neerlandesas
Arabia Saudí
Argelia
Argentina
Armenia
Aruba
Australia
Azerbaiyán
Bahamas
Bangladés
Barbados
Baréin
Belice
Benín
Bermudas
Bielorrusia
Bolivia
Bosnia-Herzegovina
Botsuana
Brasil
Brunéi
Burkina Faso
Burundi
Bután
Cabo Verde
Camboya
Camerún
Canadá
Catar
Chad
Chile
China
Ciudad del Vaticano
Colombia
Comoras
Corea Del Norte
Corea Del Sur
Costa De Marfil
Costa Rica
Cuba
Dominica
Ecuador
Egipto
El Salvador
Emiratos Árabes Unidos
Eritrea
España
Etiopía
Filipinas
Fiyi
Gabón
Gambia
Georgia
Ghana
Gibraltar
Granada
Groenlandia
Guadalupe
Guam
Guatemala
Guayana Francesa
Guernesey
Guinea
Guinea Ecuatorial
Guinea-Bisáu
Guyana
Haití
Honduras
India
Indonesia
Irán
Iraq
Isla Bouvet
Isla Christmas
Isla De Man
Isla Niue
Isla Norfolk
Islandia
Islas Åland
Islas Caimán
Islas Cocos
Islas Cook
Islas Feroe
Islas Georgia Del Sur Y Sandwich Del Sur
Islas Heard Y McDonald
Islas Malvinas
Islas Marianas Del Norte
Islas Marshall
Islas Pitcairn
Islas Salomón
Islas Turcas Y Caicos
Islas Vírgenes Británicas
Islas Vírgenes De EE. UU.
Israel
Jamaica
Japón
Jersey
Jordania
Kazajistán
Kenia
Kirguistán
Kiribati
Kuwait
Laos
Lesoto
Líbano
Liberia
Libia
Liechtenstein
Macedonia
Madagascar
Malasia
Malaui
Maldivas
Mali
Marruecos
Martinica
Mauricio
Mauritania
Mayotte
México
Micronesia
Moldavia
Mónaco
Mongolia
Montenegro
Montserrat
Mozambique
Myanmar (Birmania)
Namibia
Nauru
Nepal
Nicaragua
Níger
Nigeria
Noruega
Nueva Caledonia
Nueva Zelanda
Omán
Pakistán
Palau
Panamá
Papúa Nueva Guinea
Paraguay
Perú
Polinesia Francesa
Puerto Rico
RAE De Hong Kong (China)
RAE De Macao (China)
Reino Unido
República Centroafricana
República Del Congo
República Democrática Del Congo
República Dominicana
Reunión
Ruanda
Rusia
Sáhara Occidental
Samoa
Samoa Americana
San Bartolomé
San Cristóbal Y Nieves
San Marino
San Martín
San Pedro Y Miquelón
San Vicente Y Las Granadinas
Santa Lucía
Santo Tomé Y Príncipe
Senegal
Serbia
Seychelles
Sierra Leona
Singapur
Siria
Somalia
Sri Lanka
Suazilandia
Sudáfrica
Sudán
Suiza
Surinam
Svalbard Y Jan Mayen
Tailandia
Taiwán
Tanzania
Tayikistán
Territorio Británico Del Océano Índico
Territorios Australes Franceses
Territorios Palestinos
Timor Oriental
Togo
Tokelau
Tonga
Trinidad Y Tobago
Túnez
Turkmenistán
Turquía
Tuvalu
Ucrania
Uganda
Uruguay
Uzbekistán
Vanuatu
Venezuela
Vietnam
Wallis Y Futuna
Yemen
Yibuti
Zambia
Zimbabue
Confirmar selección